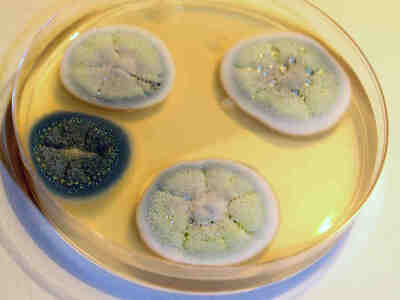
Пенициллин

Пенициллин и антибиотики
Пенициллин — первый антибиотик — полученный на основе продуктов жизнедеятельности микроорганизмов.
Пенициллин был выделен в 1928 году Александром Флемингом из штамма гриба вида Penicillium notatum на основе случайного открытия: попадание в культуру бактерий спор плесневого гриба из внешней среды оказало на бактериальную культуру бактерицидное действие.
Пенициллин: как открытие Флеминга превратилось в антибиотик
За всю историю человечества не было лекарства, которое спасло бы от смерти столько людей, сколько пенициллин. Он получил свое название от прародителя — плесневого грибка Penicillium, витающего в воздухе в виде спор.
Родина — Англия
Открытием пенициллина человечество обязано шотландскому биохимику Александру Флемингу. Хотя, конечно, то, что Флеминг натолкнулся на свойства плесени, было закономерным. Он шел к этому открытию годы.
Во время Первой мировой войны Флеминг служил военным врачом и не мог смириться с тем, что раненые после успешно проведенной операции все-таки погибали — от начавшейся гангрены или сепсиса. Флеминг стал искать средство, как предотвратить такую несправедливость.
В 1918 году Флеминг вернулся в Лондон в бактериологическую лабораторию больницы Св. Марии, в которой работал с 1906 года вплоть до самой смерти.
В 1922 году пришел первый успех, чрезвычайно похожий на историю, шесть лет спустя приведшую к открытию пенициллина.
Простуженный Флеминг, только что поместивший очередную культуру бактерий Micrococcus lysodeicticus в так называемую чашку Петри, — широкий стеклянный цилиндр с низкими стенками и крышкой, — неожиданно чихнул. Через несколько дней он открыл эту чашку и обнаружил, что в некоторых местах бактерии погибли. Судя по всему — в тех, куда попала слизь из его носа при чихании.
Флеминг начал проверять. И в результате был открыт лизоцим — естественный фермент слизи человека, животных и, как позже выяснилось, некоторых растений. Он разрушает стенки бактерий и растворяет их, но при этом безвреден для здоровых тканей. Не случайно собаки зализывают раны — этим они снижают риск их воспаления.
![]()
Пенициллин
Однако лизоцим действует на большинство бактерий довольно медленно. Кроме того, он сражается не с болезнетворными бактериями, а с сапрофитами — микроорганизмами-сожителями, которые всегда присутствуют в человеке. Лизоцим регулирует, чтобы их не стало слишком много и за счет этого они не превратились в паразитов.
После каждого опыта чашки Петри положено было стерилизовать. У Флеминга же не было привычки выбрасывать культуры и мыть лабораторную посуду сразу после эксперимента. Обычно он занимался этой малоприятной работой, когда на рабочем столе накапливалось два-три десятка чашек. Предварительно он осматривал чашки.
«Как только вы открываете чашку с культурой, вас ждут неприятности, — вспоминал Флеминг. — Обязательно что-нибудь попадет из воздуха».
И однажды, когда он занимался исследованием гриппа, в одной из чашек Петри обнаружилась плесень, которая, к удивлению ученого, растворила высеянную культуру — колонии золотистого стафилококка, и вместо желтой мутной массы виднелись капли, похожие на росу.
Чтобы проверить свое предположение о бактерицидном влиянии плесневого грибка, Флеминг пересадил несколько спор из своей чашки на питательный бульон в колбе и оставил их прорастать при комнатной температуре.
Поверхность покрылась толстой войлочной гофрированной массой. Первоначально она была белой, потом стала зеленой и, наконец, почернела. Вначале бульон оставался прозрачным. Через несколько дней он приобрел очень интенсивный желтый цвет, выработав какое-то особое вещество, которое получить в чистом виде Флемингу не удалось, так как оно оказалось очень нестойким. Выделяемое грибком желтое вещество Флеминг назвал пенициллином.
![]()
Общая структура пенициллинов
Оказалось, что даже при разведении в 500–800 раз культуральная жидкость подавляла рост стафилококков и некоторых других бактерий. Таким образом, было доказано исключительно сильное антагонистическое влияние данного вида грибка на определенные бактерии.
Обнаружилось, что пенициллин подавлял в большей или меньшей степени рост не только стафилококков, но и стрептококков, пневмококков, гонококков, дифтерийной палочки и бацилл сибирской язвы, но не действовал на кишечную палочку, тифозную палочку и возбудителей гриппа, паратифа, холеры. Чрезвычайно важным открытием было отсутствие вредного влияния пенициллина на лейкоциты человека даже в дозах, во много раз превышающих дозу, губительную для стафилококков.
Это означало безвредность пенициллина для людей.
Производство — Америка
Следующий шаг был сделан в 1938 году профессором Оксфордского университета, патологом и биохимиком Говардом Флори, который привлек к сотрудничеству Эрнста Бориса Чейна. Чейн получил высшее образование в области химии в Германии. Когда к власти пришли нацисты, Чейн, будучи евреем и сторонником левых взглядов, эмигрировал в Англию.
Эрнст Чейн продолжил исследования Флеминга. Он смог получить неочищенный пенициллин в количествах, достаточных для первых биологических испытаний сначала на животных, а затем и в клинике. После года мучительных экспериментов по выделению и очистке продукта капризных грибов удалось получить первые 100 мг чистого пенициллина. Первого пациента (полицейского с заражением крови) спасти не удалось — не хватило накопленного запаса пенициллина. Антибиотик быстро выводился почками.
Чейн привлек к работе других специалистов: бактериологов, химиков, врачей. Была сформирована так называемая Оксфордская группа.
К этому времени началась Вторая мировая война. Летом 1940 года над Великобританией нависла опасность вторжения. Оксфордская группа решает спрятать плесневые споры, пропитав бульоном прокладки пиджаков и карманов. Чейн говорил: «Если меня убьют, первым делом хватайте мой пиджак». В 1941 году впервые в истории удалось спасти от смерти человека с заражением крови — им стал 15-летний подросток.
Однако в воюющей Англии наладить массовое производство пенициллина не удалось.
Летом 1941 года руководитель группы фармаколог Говард Флори отправляется совершенствовать технологию в США.
На экстракте американской кукурузы выход пенициллина увеличился в 20 раз. Затем решили поискать новые штаммы плесени, более продуктивные, чем Penicillium notatum, когда-то прилетевший в окно Флемингу. В американскую лабораторию стали присылать образцы плесеней со всего мира. Наняли девушку Мэри Хант, закупавшую на рынке все заплесневелые продукты. И однажды Заплесневелая Мэри приносит с рынка гнилую дыню, в которой находят продуктивный штамм P. chrysogenum.
К этому времени Флори сумел убедить американское правительство и промышленников в необходимости производства первого антибиотика.
В 1943 году впервые началось промышленное производство пенициллина. Технология массового выпуска пенициллина, сразу же получившего еще и второе название — «лекарство века», была передана на предприятия Pfizer и Merck. В 1945 году выпуск фармакопейного пенициллина высокой активности составлял 15 т в год, в 1950 году — 195 т.
Советский пенициллин
В 1941 году в СССР поступили секретные данные о том, что в Англии создается мощнейший антимикробный препарат на основе какого-то вида грибков рода Penicillium. В Советском Союзе начали немедленно работать в этом направлении, и уже в 1942 году советский микробиолог Зинаида Ермольева получила пенициллин из плесени Penicillium Crustosum, взятой со стены одного из бомбоубежищ Москвы. В 1944 году Ермольева, после долгих наблюдений и исследований, решила испытать свой препарат на раненых.
Ее пенициллин стал чудом для полевых врачей и спасительным шансом для многих раненых бойцов.
Несомненно, открытие и работы Ермольевой не менее значительны, чем работы Флори и Чейна. Они спасли множество жизней и позволяли производить пенициллин, так необходимый для фронта. Однако советский препарат получали кустарным способом в количествах, совершенно не соответствующих потребностям отечественного здравоохранения.
В 1947 году во Всесоюзном научно-исследовательском химико-фармацевтическом институте (ВНИХФИ) была создана полузаводская установка. Эта технология в увеличенном масштабе легла в основу первых пенициллиновых заводов, построенных в Москве и Риге. При этом получался желтый аморфный продукт низкой активности, который к тому же вызывал повышение температуры у пациентов. В то же время пенициллин, поступавший из-за границы, не давал побочных эффектов.
Купить технологии промышленного производства пенициллина СССР не мог: в США существовал запрет на продажу любых технологий, связанных с ним. Однако Эрнст Чейн, автор и владелец английского патента на получение пенициллина нужного качества, предложил свою помощь Советскому Союзу. В сентябре 1948 года комиссия советских ученых, завершив работу, вернулась на родину. Результаты были оформлены в виде промышленных регламентов и успешно внедрены в производство на одном из московских заводов.
На церемонии вручения Нобелевской премии по физиологии и медицине, которую Флеминг, Флори и Чейн получили в 1945 году за открытие пенициллина и его лечебного эффекта, Флеминг сказал:
«Говорят, что я изобрел пенициллин. Но ни один человек не мог его изобрести, потому что это вещество создано природой. Я не изобретал пенициллин, я всего лишь обратил на него внимание людей и дал ему название».
Теги к статье
Поделиться статьёй и ссылки
Комментарии
Вы должны авторизоваться, чтобы оставлять комментарии.